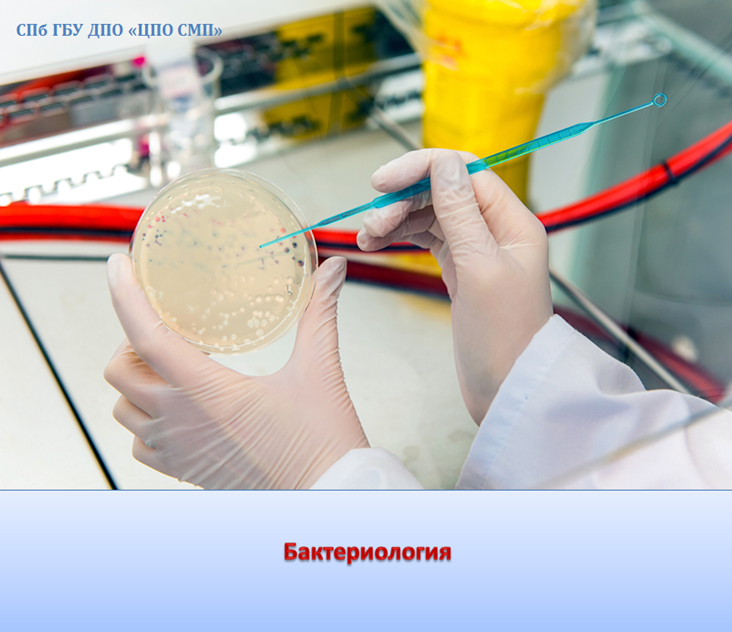

-

Сертификат
качества
Сведения об
образовательной
организации
Запись на
платное
обучение
Версия для
слабовидящих
Непрерывное медицинское образование специалистов
Центр последипломного образования специалистов медицинского профиля представляет программы:
Цикл: "Бактериология" - 150 часов/150 ZET.
Сроки обучения: по набору групп.
Курс предназначен для повышения квалификации специалистов со средним медицинским образованием по специальности «Бактериология», для осуществления профессиональной деятельности, в рамках имеющейся квалификации.
Программа построена на основе модульно – компетентностного подхода, практикоориентирована, развивающего характера. Обучающимся предлагается изучить следующие темы:
Модуль 1 «Общепрофессиональный»:
- Профилактическая медицина
- Медицинское право
- Медицинская этика и деонтология
- Психология
- Основы трудового законодательства
- Инфекционный контроль
- Инфекционная безопасность
- Оказание помощи при неотложных состояниях
Модуль 2 «Специальность»:
- Микробиология.
Обучение проводится очно. Для оформления на курс необходимо оформить заявку на Портале НМО.
По окончанию обучения выдаётся удостоверение установленного образца и получение 150 зет на Портале НМО Минздрава России.
Контакты для связи и получения информации по данному циклу:
- тел. 719-69-18



